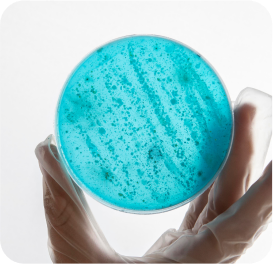

Our Philosophy, Blending Nature and
Science to Empower Your Brand


Where Herbal Wisdom Meets
Modern Innovation
Theerah Cosmetics was founded with a vision to bridge traditional,
herbal wisdom and modern cosmetic science. Our mission is to
empower brands globally with products that are effective, safe, and
backed by decades of formulation expertise. From nourishing hair
oils to advanced serums, we craft solutions that help your brand
stand out.

We operate GMP & ISO-certified manufacturing units equipped with advanced
machinery, automated filling lines & stringent hygiene protocols. Our large-scale
capacity ensures efficient production without compromising on quality
Our Journey
from Lab to Label

Scalable
production lines
Automated filling &
packaging units

Adherence to international
safety standards
In-House
R&D Excellence
Our in-house R&D labs, led by expert chemists and formulators, blend herbal actives with clinical-grade ingredients to craft precise, market-ready solutions tailored to your brand’s needs.

Custom formulation
development
Stability &
microbiological testing

Ingredient efficacy
analysis

Trend-driven product
innovation

"We were looking for a manufacturing partner who could maintain premium quality at scale — and Theerah delivered beyond expectations. Every batch has been consistent, reliable, and aligned perfectly with our brand standards."
FAQs
What is your minimum order quantity?
We offer flexible MOQs to support both startups and established brands.
Can I customize formulations?
Yes, we offer customization based on your specific requirements.